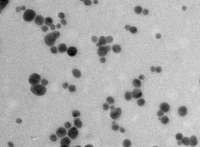

Nano Bạc (Nano Silver)
100.000₫
Láng Hạ, Hà Nội
cung cấp nano bạc giá thành rẻ, số lượng lớn ứng dụng trong nuôi trồng thủy sản, chăn nuôi, trồng trọt và các ứng dụng khác trong y tế...
Thông số kỹ thuật của nano bạc
Tên sản phẩm: Dung dịch nano bạc
Cảm quan: Màu vàng nâu dạng lỏng
Dung môi: Nước tinh khiết
Độ tinh khiết: 99.5%
Hoá chất sử dung: Merck/ Bayer
Chất bảo vệ: Tinh bột (dạng tan được)
Kích thước hạt trung bình: 12 nm
Nồng độ: 500 ppm
Quy cách đóng gói: can nhựa/5l-20l

Hình 1: Mầu của sản phẩm nano bạc ở các nồng độ khác nhau
Hình 2: Ảnh TEM của hạt bạc trong dung dịch
Liên hệ: Cô Phương-Trưởng phòng kinh doanh
Mobile: 01252825104
Từ khóa gợi ý:
Nano Silver
Nano Silver
Silver Nano
Nano Bạc
Nano Bạc
Bạc Nano
Nano Silver Nồi
Mummy Nano Silver
Chảo Nano Silver
Lõi Nano Silver
Nano Silver Bbc011
Mp4 Nano Silver
Daewoo Nano Silver
Wesser Nano Silver
Nano Silver Wesser
Samsung Silver Nano
Bear Nano Silver
Loi Nano Silver
Loc Nano Silver
Nano Silver 1092
HẾT HẠN
0125 282 5104
| Mã số : | 8743568 |
| Địa điểm : | Hà Nội |
| Hình thức : | Cần bán |
| Tình trạng : | Hàng mới |
| Hết hạn : | 27/10/2020 |
| Loại tin : | Thường |
Để mua hàng an toàn trên Rao vặt, quý khách vui lòng không thực hiện thanh toán trước cho người đăng tin!
Gợi ý cho bạn












Bình luận